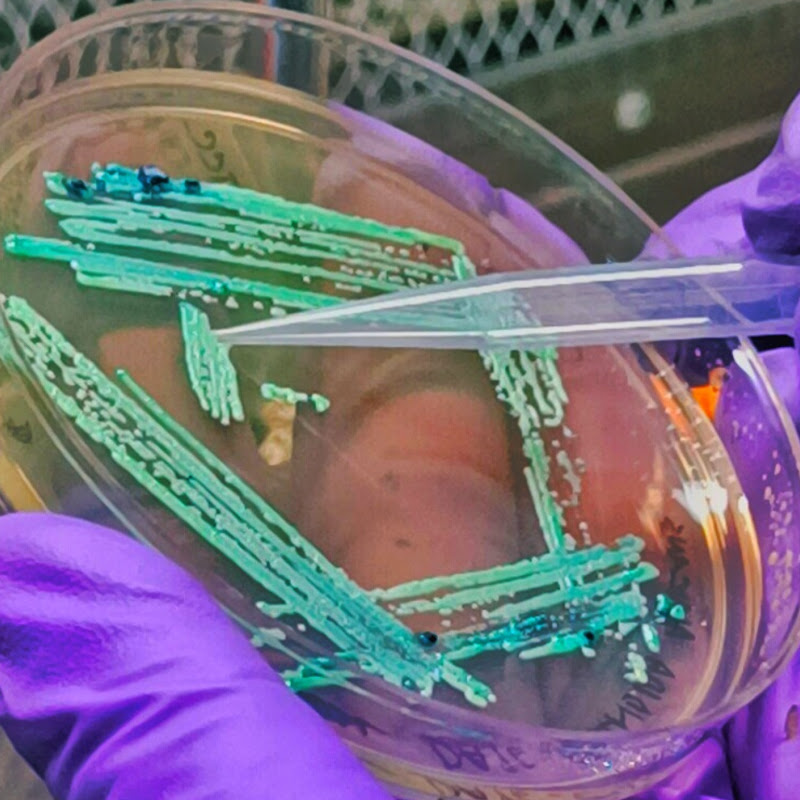

HeredityBioAcademy
@hereditybioacademy7062HeredityBioAcademy is a Science and Education YouTube creator with 6.3K subscribers and 3.7M total views. The channel covers biotechnology, molecular biology, microbiology, life sciences, lab techniques. Active for 3 years, the channel publishes about 4 videos per week. Videos average 4.1K views each. Based in India, the channel's primary language is English. YouTube channels with 1K–10K sub channels typically charge between $50 and $500 per sponsored video. Book a sponsorship directly on TrySpansa.
Niches
About
Welcome to Heredity Bioacademy, created by the dedicated team at Heredity Biosciences! This channel is designed to promote awareness of hands-on experimental techniques in the life sciences. Join us as we explore a variety of topics, including molecular biology, microbiology, biotechnology, and more. Our goal is to provide valuable insights, practical demonstrations, and educational resources to empower students, researchers, and enthusiasts in their scientific journey. Subscribe to stay updated on our latest videos and enhance your understanding of life sciences through engaging and informative content! Connect us: Heredity Biosciences, Plot No: 818, Mayfair Lagoon Road, Jayadev Vihar, Bhubaneswar /7381298980 #hereditybioacademy #hereditybio #hereditybiosciences
Recent Videos
Channel data updated May 2026
Sponsorship Pricing
This creator hasn't set their rates yet. Estimate typical rates for their niche:
Rate Calculator
TrySpansa OriginalEnter your channel stats to estimate sponsorship rates.
● Free · No credit card required
Estimated pricing — negotiate directly
Related Creators
Manual do Mundo
20,300,000 subs
Polinka_girla (Полинка и Оператор)
6,990,000 subs
TheDadLab
5,140,000 subs
MAX Gyan
3,770,000 subs
Veritasium en español
2,880,000 subs
MAD SCIENCE
2,600,000 subs
Manual do Mundo
20,300,000 subs
Polinka_girla (Полинка и Оператор)
6,990,000 subs
TheDadLab
5,140,000 subs
MAX Gyan
3,770,000 subs
Veritasium en español
2,880,000 subs
MAD SCIENCE
2,600,000 subs
Manual do Mundo
20,300,000 subs
Polinka_girla (Полинка и Оператор)
6,990,000 subs
TheDadLab
5,140,000 subs
MAX Gyan
3,770,000 subs
Veritasium en español
2,880,000 subs
MAD SCIENCE
2,600,000 subs
Similar English Science Creators
Karim's Biology
12,500 subs
US Navy Research
12,100 subs
DBX Labs
12,100 subs
G Star Education
11,700 subs
MR. EVERYTHING EXPERIMENTS
11,700 subs
SkyWatcher
11,500 subs
Karim's Biology
12,500 subs
US Navy Research
12,100 subs
DBX Labs
12,100 subs
G Star Education
11,700 subs
MR. EVERYTHING EXPERIMENTS
11,700 subs
SkyWatcher
11,500 subs
Karim's Biology
12,500 subs
US Navy Research
12,100 subs
DBX Labs
12,100 subs
G Star Education
11,700 subs
MR. EVERYTHING EXPERIMENTS
11,700 subs
SkyWatcher
11,500 subs











